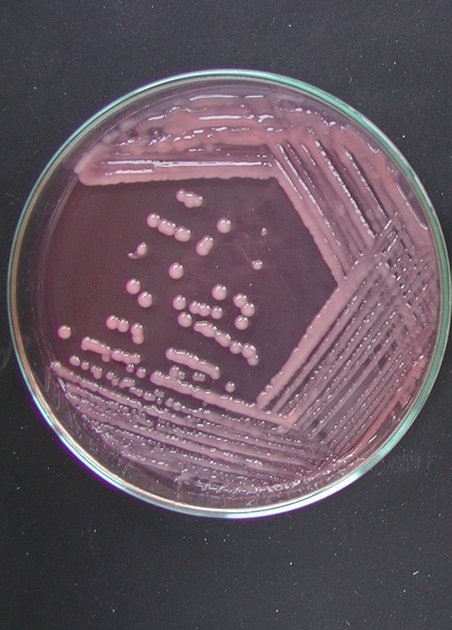

Reunião Relare debate potencial dos inoculantes microbianos no Brasil
Por Lebna Landgraf, Embrapa Soja
A 21ª Reunião da Rede de Laboratórios para Recomendação, Padronização e Difusão de Tecnologias de Inoculantes Microbianos de Interesse Agrícola (Relare) será realizada dias 25 e 26 de junho, a partir das 8h30, no Buffet Planalto, em Londrina (PR), para debater os resultados e os avanços de pesquisas para inoculantes microbiológicos de interesse agrícola e subsidiar o planejamento da pesquisa e de transferência de tecnologia.
A expectativa é reunir cerca de 200 participantes entre pesquisadores, professores, técnicos, produtores rurais e representantes das indústrias nacionais de bioinsumos, do Ministério da Agricultura e Pecuária e de outras entidades. “A Relare tem o intuito de auxiliar na transferência dos resultados da pesquisa para a indústria; ajudar na normatização de regras para a certificação de produtos biológicos de qualidade; estimular o mercado nacional promovendo o uso de novos produtos e apoiar a difusão de novas tecnologias associadas ao uso de microrganismos promotores de crescimento de plantas no Brasil”, destaca o pesquisador Marco Antonio Nogueira, da Embrapa Soja, presidente da Relare.
A palestra de abertura a ser realizada no dia 25, às 8h45, trará um panorama sobre os Inoculantes para o Brasil e para o mundo, com destaque para a capacidade produtiva e competitiva da indústria nacional e será ministrada por Solon Cordeiro Araújo, conselheiro da Associação Nacional dos Produtores e Importadores de Inoculantes (ANPII). De acordo com levantamento da ANPII, o setor de inoculantes biológicos vem apresentando crescimento continuado ao longo dos últimos 4 anos, com média anual de 14,7%, sendo a cultura da soja a que mais adota essa tecnologia.
Em 2023, as empresas comercializaram cerca de 141 milhões de doses de inoculantes no Brasil, segundo dados da ANPII. Entre as culturas agrícolas, a soja lidera a utilização de inoculantes, com 77% do valor das vendas da indústria (83% em doses), seguida pelo milho, com 16% (13% em doses) e cana com 2,5% (1,3% em doses).
Em 2023, os inoculantes biológicos baseados em bactérias Bradyrhizobium representaram 72,7% em número de doses. Já produtos com as bactérias Azospirillum e Pseudomonas representaram 26,7% das doses comercializadas no Brasil. “O cenário mostra que outras culturas ainda trazem enormes oportunidades de crescimento na adoção e desenvolvimento para os inoculantes no país, com potencial de expansão nos benefícios ambientais e econômicos para nossa produção agrícola”, defende Solon.
21ª Reunião da Rede de Laboratórios para Recomendação, Padronização e Difusão de Tecnologias de Inoculantes Microbianos de Interesse Agrícola (Relare)
Data: 25 e 26 de junho
Local: Buffet Planalto, em Londrina
Inscrições e informações: reuniaodesoja.com.br/relare